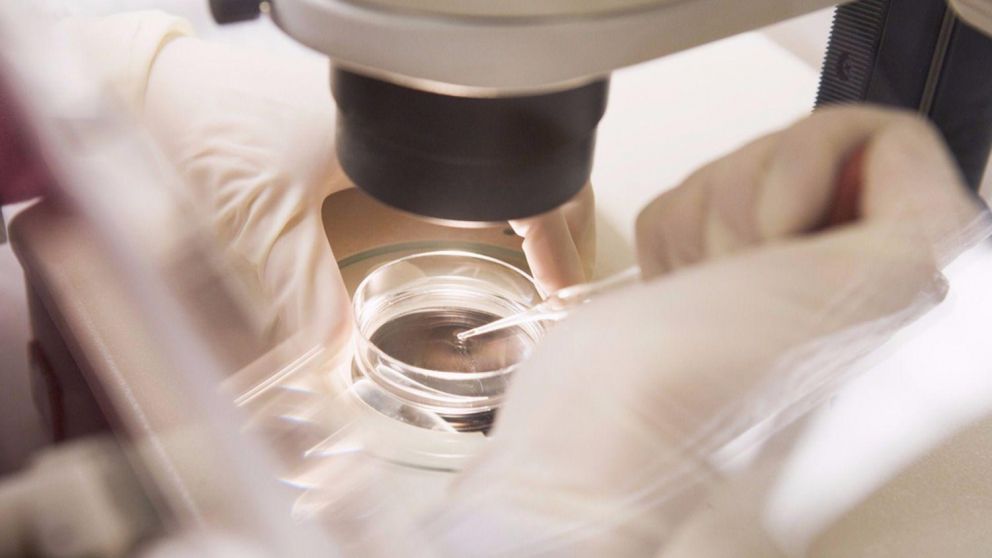
Inseminaci�n artificial. Los procedimientos son largos y costosos. (Imagen ilustrativa)

Médico en fertilidad utilizó su semen para embarazar a más de 50 mujeres
El especialista atendía en un consultorio en Indiana, Estados Unidos. Las pacientes jamás dieron el consentimiento.
Un médico de fertilidad de Indiana (EE.UU.) utilizó su propio esperma para inseminar artificialmente a sus pacientes sin su consentimiento entre la década de los 70 y los 80, habiendo sido confirmado hasta la fecha como el padre de al menos 50 hijos, muchos de los cuales solo han descubierto recientemente quién es su progenitor.
Heather Woock, una de las hijas del doctor Donald Cline, supo la verdad después de que un desconocido contactara con ella en agosto de 2017 para decirle que era su hermanastro, según relató a The Atlantic. Aunque, en un primer momento, la mujer no le creyó, los mensajes siguieron llegando, a los que se sumaron los de otras personas que aseguraban ser sus medio hermanos. Todos ellos la habían rastreado en Facebook a través de su nombre de usuario en la cuenta de la web Ancestry.com, que Woock creó cuando su esposo le regaló una prueba de ADN para que conociera su procedencia.
El hallazgo
Una de las primeras personas que descubrió que Cline es su padre biológico fue Jacoba Ballard, que empezó a buscar a sus hermanastros en 2014. Cuando encontró a los primeros familiares, siguieron buscando juntos al donante del esperma hasta que, finalmente, dieron con Cline. En 2016, consiguieron reunirse con el médico, que, supuestamente, admitió haber usado su propio esperma para inseminar a unas 50 pacientes. Según les dijo, sus registros médicos habían sido destruidos años antes.
La admisión finalmente condujo a una investigación criminal y Cline fue acusado de mentir a los investigadores. El médico retirado, que ahora tiene 80 años, recibió una sentencia suspendida de un año en diciembre de 2017. No se presentaron más cargos contra él, porque la ley de Indiana no prohíbe de forma específica que los doctores de fertilidad usen su propio esperma.
Hasta ahora, las pruebas de ADN de los servicios especializados, como 23andMe y Ancestry.com, confirmaron que al menos 50 niños fueron engendrados por Cline, pudiendo ser el número mucho mayor si se tiene en cuenta la cantidad de personas que nunca se han realizado pruebas de ADN. Entretanto, varios de los hijos de Cline se mantienen en contacto a través de un grupo de Facebook.